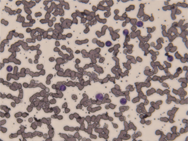

- USB3.0
- CMOS
- Cマウント/CSマウント
- ソフトウェア付属
高解像度でも高速フレームレート
画像追随性に優れたUSB3.0顕微鏡用カラーデジタルカメラ
高速データ転送規格USB3.0完全対応により、従来のUSB2.0モデルよりもデータ転送速度が飛躍的に向上しました。
高解像度時においてもより高いフレームレート(従来の約3倍)が得られるので、画像の追随性が向上し、速い動きの試料も鮮明に捉えます。
Windows用、およびMac用の制御ソフトウェアが標準付属。高機能なWindows用ソフトウェアには計測機能も搭載されています。対応OSはWindows XP〜10、MacOS 10.7〜10.11。Directshow・TWAIN用のプラグインも標準付属。さらにSDKも無償提供可能です。
外部トリガを搭載しているので、センサを併用した自動撮影等も可能。様々なシーンでご利用頂けます。
映像素子はカラーCMOSを搭載。スタンダードな顕微鏡用デジタルカメラです。明視野・位相差などの観察法に適しており、ライフサイエンス、臨床、教育、工業・産業分野など幅広い用途で使用することができます。
顕微鏡への接続部は、最も一般的なCマウント。CSマウントにも対応します。メーカーを問わず、ほとんどの顕微鏡に取り付け可能です。ご利用中の顕微鏡への接続の可否はお気軽にご相談ください。
| WRAYCAM-NT500 500万画素USB3.0顕微鏡用カラーカメラ USBケーブル付、外部トリガ端子付 在庫なし |
販売終了 |
|---|---|
| WRAYCAM-NT500アダプタセット USBカメラとCマウントアダプタユニバーサルタイプNC045・ 30mm変換アダプタ・30.5mm変換アダプタのセット 在庫なし |
販売終了 |
| WRAYCAM-NT1000 1000万画素USB3.0顕微鏡用カラーカメラ USBケーブル付、外部トリガ端子付 在庫なし |
販売終了 |
| WRAYCAM-NT1000アダプタセット USBカメラとCマウントアダプタユニバーサルタイプNC045・ 30mm変換アダプタ・30.5mm変換アダプタのセット 在庫なし |
販売終了 |
特徴FEATURES
WRAYCAM-NTシリーズは、USB3.0搭載の顕微鏡用USBカラーデジタルカメラのスタンダードモデルです。
パソコンにUSB接続してご利用いただく顕微鏡用デジタルカメラです。
観察中の試料をカメラを通してリアルタイムにパソコンの画面に映し出すことができ、その様子を静止画や動画として記録することができます。
USB3.0搭載により、従来のモデルよりもデータ転送速度が飛躍的に向上しました。同じ解像度で比較した場合、WRAYCAM-NFシリーズのおよそ3倍のフレーム
レートが得られます。
像の追随性が向上したため、焦点調整時や標本移動時の操作性も格段に向上しました。
※USB3.0のパフォーマンスを最大に引き出すには、USB3.0ポートを有するパソコンをご利用下さい。USB2.0ポートでも使用可能ですが、転送速度はUSB2.0の速度(最大480Mbps)となります。


※USB接続時の速度は、お客さまの環境により異なります。
外部トリガ
外部トリガを搭載しているので、センサを併用した自動撮影等も可能。様々なシーンでご利用頂けます。

高機能なソフトウェアが標準付属
WRAYCAMは、USBケーブル経由でパソコンに接続し、パソコン画面上で各種設定や撮影操作を行うカメラです。
制御ソフトウェアは、Windows用の"WraySpect"とMac用の"Captman"が標準装備。WIndowsでもMacでもご利用いただくことが出来ます。
Windows用の制御ソフトウェア"WraySpect"は多機能なソフトウェアです。
顕微鏡像の静止画や動画を簡単に撮影することができます。タイムラプス撮影も出来ます。パソコンモニタ上で顕微鏡像をリアルタイムに確認できるので、標本の位置合わせや焦点の確認が非常に簡単です。さらに撮影した画像の画像処理や、HDR合成、計測機能などが搭載されています。
Mac対応のソフトウェア"Captman"では、顕微鏡像をリアルタイムに確認したり、静止画及び動画の撮影を行うことができます。ホワイトバランスや露出の調整も、オート/マニュアルで調整可能です。シンプルな画面構成で操作もとても簡単です。
お使いいただくには、ご利用のパソコンが推奨動作環境を満たしている必要があります。推奨動作環境および付属ソフトウェアの詳細は以下のリンク先ページをご覧下さい。
| WrayView (Windows対応) |
WraySpect (Windows対応) |
Captman (Mac対応) |
ほぼ全ての顕微鏡に取り付け可能。汎用性・互換性のあるカメラです。
最も一般的なマウントであるCマウントを採用。 C/CSマウント変換リングを外せばCSマウントにも対応します。
また、オプション品のCマウントアダプタ ユニバーサルタイプや変換アダプタを併用すれば、Cマウント、CSマウントのみならず、鏡筒内径23.2mmや30mm、30.5mmの接眼部に取付けることも可能です。
標準的な顕微鏡であれば他社製の顕微鏡であってもほぼ全ての顕微鏡でご利用いただけます。
三脚用ネジ穴も付いていますので三脚に装着することもできます。
目的に応じた倍率のCマウントアダプタユニバーサルタイプをご利用ください。
WRAYCAM-NT500,WRAYCAM-NT1000ともに約0.4〜0.5倍程度のCマウントアダプタユニバーサルタイプとの併用が最適です。オプション品のCマウントアダプタユニバーサルタイプNC045などをご利用ください。
NT500 における各Cマウントアダプタユニバーサルタイプでの撮影範囲

NT1000 における各Cマウントアダプタユニバーサルタイプでの撮影範囲

仕様SPECIFICATION
本仕様表は左右にスクロール可能です。
| 仕様 | WRAYCAM-NT500 | WRAYCAM-NT1000 |
|---|---|---|
| センサータイプ | CMOS | |
| 映像素子 | 1/2.5″ | 1/2.3″ |
| ピクセルサイズ | 2.2μmx2.2μm | 1.67μmx1.67μm |
| 解像度 | 2584 X 1936 | 3656 X 2740 |
| 1272 X 952 | 1824 X 1362 | |
| 632 X 472 | 1640 X 1228 | |
| 1272 X 952bin | 908 X 672 | |
| 632 X 472bin | 1824 X 1362bin | |
- |
908 X 672bin | |
| フィルタ | RGB Bayer Pattern | |
| マウント | Cマウント/ CSマウント | |
| フレームレート | 15fps(2584 X 1936) | 7fps(3656 X 2740) |
| 42fps(1272 X 952) | 18fps(1824 X 1362) | |
| 115fps(632 X 472) | 28fps(1640 X 1228) | |
| 32fps(1272 X 952bin) | 41fps(908 X 672) | |
| 50fps(632 X 472bin) | 7fps(1824 X 1362bin) | |
| - | 23fps(908 X 672bin) | |
| SDカード | - | |
| RGB出力 | 24 bit | |
| 露出制御 | オート/マニュアル | |
| 露出時間 | ||
| - WraySpect | 0.1mS-2.5S | 0.1mS-3.0S |
| - Captman | 0.1mS-2.5S | 0.1mS-3.0S |
| ファイル保存形式 | ||
| - WraySpect | 静止画:.jpg/.bmp/.tif/.raw 動画:.avi | |
| - Captman | 静止画:.jpg/.bmp/.tif/.png/.raw 動画:.mov | |
| - HDMI | - | |
| ホワイトバランス | オート/マニュアル | |
| スキャンモード | プログレッシブ | |
| シャッター | Electronic rolling shutter | |
| 量子効率 | ![]() |
![]() |
| (グラフをクリックすると拡大表示されます。) | ||
| 感度 | 1.4V/Lux-sec(550nm) | 0.31V/lux-sec (550nm) |
| フィルタ透過率 | ![]() (グラフをクリックすると拡大表示されます。) |
|
| SDK | Windows (XP/Vista/WIN7/WIN8/WIN10) 32/64bit Mac OS X(10.7/10.8/10.9/10.10/10.11) 64bit |
|
| SDK言語 | Windows 32/64bit:C++ Mac 64bit:C++ |
|
| S/N 比 | 35.5dB | 34dB |
| ダイナミックレンジ | >60dB | 65.2dB |
| HDMI 映像出力 | - | |
| 電源出力 / 電源入力 | - | |
| 動作温度 / 動度湿度 | 0~60℃ / 45~85%(但し結露しないこと) | |
| OSDディスプレイ | - | |
| カメラ本体寸法(W×D×H) | 104×83×36(mm) | |
| 本体重量約 | 358g | |
| USBケーブル長さ | 1.5m | |
| HDMIケーブル長さ | - | |
| システムチャート | WRAYCAM-NTシリーズ システムチャートPDFファイル(234KB) | |
| 取扱説明書ダウンロード | 取扱説明書PDFファイル(8.27MB) | |
| カタログダウンロード | WRAYCAM-NTシリーズ カタログPDFファイル(3.01MB) | |
関連製品OPTION
WRAYCAM-NTのオプション品



他社製顕微鏡用Cマウントアダプタ

オリンパス・ニコン・ライカ・ツァイス製顕微鏡用のCマウントアダプタをご用意しております。
光学系の無いダイレクトアダプタ(1倍)のほか、オリンパス・ニコン用には縮小光学系の入ったCマウントアダプタも複数種類取り揃えております。カメラのセンサーサイズに応じて、適切な倍率のアダプタをお選びください。